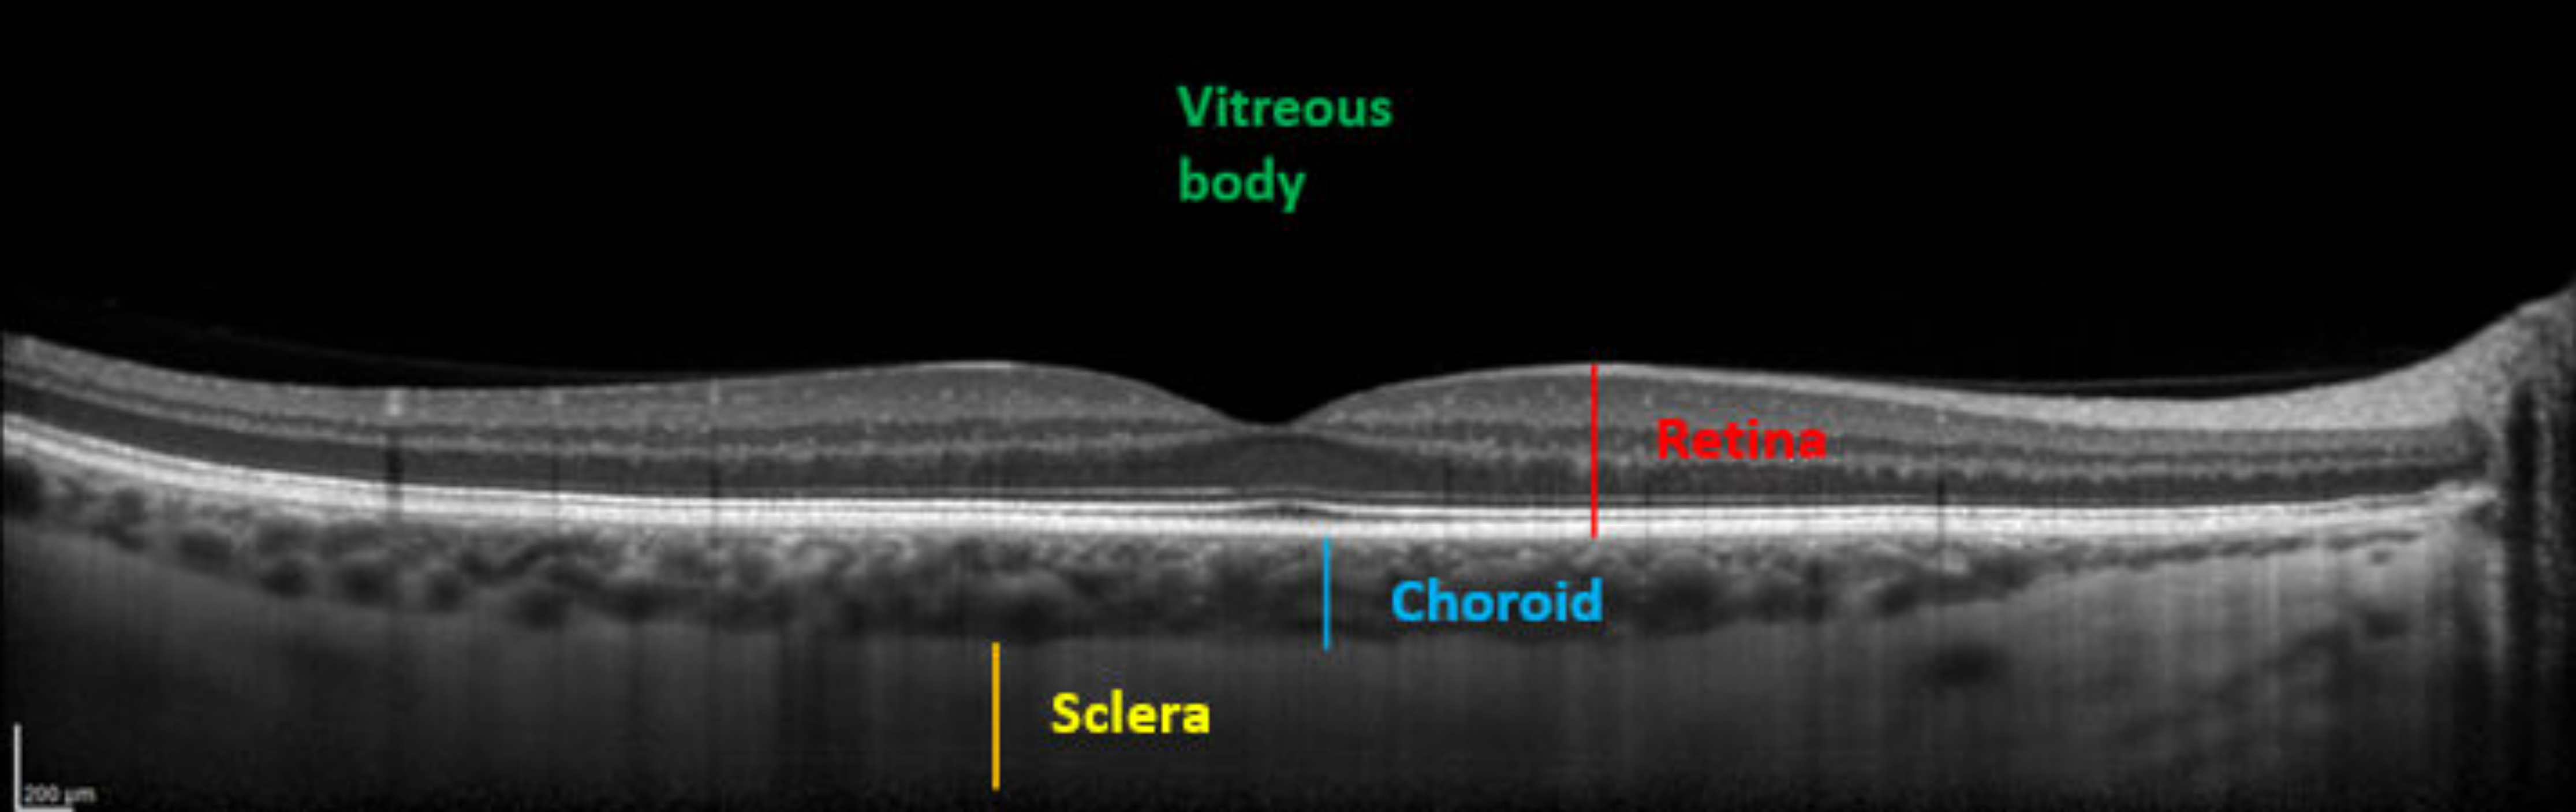
Medicina 58 00408 g003

Effect of SCUBA Diving on Ophthalmic Parameters
Abstract
:1. Introduction
2. Methods
2.1. Patients and Timing of the Study
2.2. Data Acquisition
2.2.1. Ophthalmic Measurements
2.2.2. Flow-Mediated Dilation (FMD)
2.2.3. Post Diving Vascular Gas Emboli (VGE)
3. Statistical Analysis
4. Results
4.1. Generalities
4.2. Diving Related
4.3. Ophthalmological
5. Discussion
5.1. Subfoveal Choroidal Thickness
5.2. Flow-Mediated Dilation (FMD) and Vascular Gas Emboli
5.3. Central Serous Chorioretinopathy
5.4. Intraocular Pressure
Goenadi et al. suggest that in contrast with swimming goggles, diving masks can induce small decrease of 0.43 mmHg in IOP after diving [64]. All divers wore diving masks (different from swimming goggles), respected mask pressure normalization during diving, and no mask squeeze was observed.
Corneal parameters as central corneal thickness and external curvature radius have influence on IOP measurements [65]. Increased pachymetry is associated with overestimated IOP measures, which also does not explain the results. Intraocular bubbles might block trabecular outflow, increasing IOP.
Fadini et al. interestingly showed that patients without any cardiovascular risk factors but suffering from ocular hypertension and primary open-angle glaucoma (POAG) had both FMD and endothelial progenitor cell (EPC) reduced [66]. It seems likely that chronic reduced FMD and endothelial dysfunction increase IOP. However, it was not demonstrated in transient FMD variation. No other description of decreased IOP after SCUBA diving was found on Pubmed. In contrast to our results, Maverick et al. showed increase IOP post-dive negatively correlated to pachymetry [67].
5.5. Pachymetry
6. Conclusions
Author Contributions
Funding
Institutional Review Board Statement
Informed Consent Statement
Data Availability Statement
Acknowledgments
Conflicts of Interest
Abbreviations
| BP | Blood pressure |
| CSC | Central Serous Chorioretinopathy |
| FMD | Flow-mediated dilation |
| HR | Heart rate |
| IOP | Intraocular pressure |
| KR: | Keratometry |
| NO | Nitric Oxide |
| PACHY | Pachymetry |
| SD-OCT | Spectral-Domain |
| SFCT | Subfoveal choroidal thickness |
| TTE | Transthoracic echocardiography |
| VGE | Vascular gas emboli |
References
- Butler, F.K. Diving and hyperbaric ophthalmology. Surv. Ophthalmol. 1995, 39, 347–366. [Google Scholar] [CrossRef] [Green Version]
- Merle, H.; Drault, J.N.; Gerard, M.; Alliot, E.; Mehdaoui, H.; Elisabeth, L. Retinal vein occlusion and deep-sea diving. J. Français d’Ophtalmol. 1997, 20, 456–460. [Google Scholar]
- Iordanidou, V.; Gendron, G.; Khammari, C.; Rodallec, T.; Baudouin, C. Choroidal Ischemia Secondary to a Diving Injury. Retin. Cases Brief Rep. 2010, 4, 262–265. [Google Scholar] [CrossRef] [PubMed]
- Cochard, G.; Lacour, J.; Egreteau, J. A Propos d’un accident Oculaire de Plongée Sous-Marine. 1996. Available online: https://www.semanticscholar.org/paper/A-propos-d'un-accident-oculaire-de-plong%C3%A9e-Cochard-Lacour/8b891aa6732b66070eb6c2ce519014522ef55755#citing-papers (accessed on 5 August 2021).
- Macarez, R.; Dordain, Y.; Hugon, M.; Kovalski, J.-L.; Guigon, B.; Bazin, S.; May, F.; Colin, J. Retentissement à long terme de la plongée sous-marine sur le champ visuel, la vision des couleurs et la sensibilité au contraste du plongeur professionnel. J. Français d’Ophtalmol. 2005, 28, 825–831. [Google Scholar] [CrossRef]
- Chung, Y.-R.; Kim, J.W.; Choi, S.-Y.; Park, S.W.; Kim, J.H.; Lee, K. subfoveal Choroidal Thickness and Vascular Diameter in Active and Resolved Central Serous Chorioretinopathy. Retina 2018, 38, 102–107. [Google Scholar] [CrossRef]
- Semeraro, F.; Morescalchi, F.; Russo, A.; Gambicorti, E.; Pilotto, A.; Parmeggiani, F.; Bartollino, S.; Costagliola, C. Central Serous Chorioretinopathy: Pathogenesis and Management. Clin. Ophthalmol. 2019, 13, 2341–2352. [Google Scholar] [CrossRef] [Green Version]
- World Medical Association. World Medical Association Declaration of Helsinki: Ethical principles for medical research involving human subjects. JAMA 2013, 310, 2191–2194. [Google Scholar] [CrossRef] [Green Version]
- Lazari, K.C.; Karpathaki, M.N.; Linardakis, M.; Christodoulakis, E.V. Evaluation of differences in Intraocular Pressure (IOP) measurement between Tonoref III and Goldmann Applanation Tonometry (GAT). Investig. Ophthalmol. Vis. Sci. 2019, 60, 2420. [Google Scholar]
- Myers, K.J.; Scott, C.A. The non-contact (“air puff”) tonometer: Variability and corneal staining. Am. J. Optom. Physiol. Opt. 1975, 52, 36–46. [Google Scholar] [CrossRef]
- Margolis, R.; Spaide, R.F. A Pilot Study of Enhanced Depth Imaging Optical Coherence Tomography of the Choroid in Normal Eyes. Am. J. Ophthalmol. 2009, 147, 811–815. [Google Scholar] [CrossRef]
- Pyke, K.E.; Tschakovsky, M.E.; Bandi, E.; Bernareggi, A.; Grandolfo, M.; Mozzetta, C.; Augusti-Tocco, G.; Ruzzier, F.; Lorenzon, P. The relationship between shear stress and flow-mediated dilatation: Implications for the assessment of endothelial function. J. Physiol. 2005, 568, 357–369. [Google Scholar] [CrossRef]
- Corretti, M.C.; Anderson, T.J.; Benjamin, E.; Celermajer, D.; Charbonneau, F.; Creager, M.A.; Deanfield, J.; Drexler, H.; Gerhard-Herman, M.; Herrington, D.; et al. Guidelines for the ultrasound assessment of endothelial-dependent flow-mediated vasodilation of the brachial artery: A report of the International Brachial Artery Reactivity Task Force. J. Am. Coll. Cardiol. 2002, 39, 257–265. [Google Scholar] [CrossRef] [Green Version]
- Areas, G.P.T.; Mazzuco, A.; Caruso, F.R.; Jaenisch, R.B.; Cabiddu, R.; Phillips, S.A.; Arena, R.; Borghi-Silva, A. Flow-mediated dilation and heart failure: A review with implications to physical rehabilitation. Heart Fail. Rev. 2019, 24, 69–80. [Google Scholar] [CrossRef]
- Germonpré, P.; Papadopoulou, V.; Hemelryck, W.; Obeid, G.; Lafère, P.; Eckersley, R.J.; Tang, M.-X.; Balestra, C. The use of portable 2D echocardiography and ’frame-based’ bubble counting as a tool to evaluate diving decompression stress. Diving Hyperb. Med. J. 2014, 44, 5–13. [Google Scholar]
- Theunissen, S.; Schumacker, J.; Guerrero, F.; Tillmans, F.; Boutros, A.; Lambrechts, K.; Mazur, A.; Pieri, M.; Germonpré, P.; Balestra, C. Dark chocolate reduces endothelial dysfunction after successive breath-hold dives in cool water. Eur. J. Appl. Physiol. 2013, 113, 2967–2975. [Google Scholar] [CrossRef]
- Theunissen, S.; Balestra, C.; Boutros, A.; De Bels, D.; Guerrero, F.; Germonpré, P. The effect of pre-dive ingestion of dark chocolate on endothelial function after a scuba dive. Diving Hyperb. Med. J. 2015, 45, 4–9. [Google Scholar]
- Theunissen, S.; Guerrero, F.; Sponsiello, N.; Cialoni, D.; Pieri, M.; Germonpré, P.; Obeid, G.; Tillmans, F.; Papadopoulou, V.; Hemelryck, W.; et al. Nitric oxide-related endothelial changes in breath-hold and scuba divers. Undersea Hyperb. Med. 2013, 40, 135–144. [Google Scholar]
- Levenez, M.; Lambrechts, K.; Mrakic-Sposta, S.; Vezzoli, A.; Germonpré, P.; Pique, H.; Virgili, F.; Bosco, G.; Lafère, P.; Balestra, C. Full-Face Mask Use during SCUBA Diving Counters Related Oxidative Stress and Endothelial Dysfunction. Int. J. Environ. Res. Public Health 2022, 19, 965. [Google Scholar] [CrossRef]
- Germonpré, P.; Balestra, C. Preconditioning to Reduce Decompression Stress in Scuba Divers. Aerosp. Med. Hum. Perform. 2017, 88, 114–120. [Google Scholar] [CrossRef]
- Balestra, C.; Theunissen, S.; Papadopoulou, V.; Le Mener, C.; Germonpré, P.; Guerrero, F.; Lafère, P. Pre-dive Whole-Whole Body Vibration Better Reduces Decompression Induced Vascular Gas Emboli than Oxygenation or a Combination of Both. In Physiology in Extreme Conditions: Adaptation and Unexpected Reactions; Electronic Edition; Trivella, M.G., Capobianco, E., L’Abbate, A., Eds.; Frontiers Media: Lausnne, Switzerland, 2017. [Google Scholar]
- Ferrara, M.; Lugano, G.; Sandinha, M.T.; Kearns, V.R.; Geraghty, B.; Steel, D.H.W. Biomechanical properties of retina and choroid: A comprehensive review of techniques and translational relevance. Eye 2021, 35, 1818–1832. [Google Scholar] [CrossRef]
- Ethier, C.R.; Johnson, M.; Ruberti, J. Ocular Biomechanics and Biotransport. Annu. Rev. Biomed. Eng. 2004, 6, 249–273. [Google Scholar] [CrossRef] [Green Version]
- Nickla, D.L.; Wallman, J. The multifunctional choroid. Prog. Retin. Eye Res. 2010, 29, 144–168. [Google Scholar] [CrossRef] [Green Version]
- Wallman, J.; Wildsoet, C.; Xu, A.; Gottlieb, M.D.; Nickla, D.L.; Marran, L.; Krebs, W.; Christensen, A.M. Moving the retina: Choroidal modulation of refractive state. Vis. Res. 1995, 35, 37–50. [Google Scholar] [CrossRef] [Green Version]
- Akhtar, Z.; Rishi, P.; Srikanth, R.; Rishi, E.; Bhende, M.; Raman, R. Choroidal thickness in normal Indian subjects using Swept source optical coherence tomography. PLoS ONE 2018, 13, e0197457. [Google Scholar] [CrossRef] [Green Version]
- Karimi, S.; Entezari, M.; Ramezani, A.; Nikkhah, H.; Fekri, Y.; Kheiri, B. Choroidal thickness in healthy subjects. J. Ophthalmic Vis. Res. 2018, 13, 39–43. [Google Scholar] [CrossRef] [Green Version]
- Tan, C.; Ouyang, Y.; Ruiz, H.; Sadda, S.R. Diurnal Variation of Choroidal Thickness in Normal, Healthy Subjects Measured by Spectral Domain Optical Coherence Tomography. Investig. Opthalmol. Vis. Sci. 2012, 53, 261–266. [Google Scholar] [CrossRef]
- Lambrechts, K.; Pontier, J.-M.; Balestra, C.; Mazur, A.; Wang, Q.; Buzzacott, P.; Theron, M.; Mansourati, J.; Guerrero, F. Effect of a single, open-sea, air scuba dive on human micro- and macrovascular function. Eur. J. Appl. Physiol. 2013, 113, 2637–2645. [Google Scholar] [CrossRef]
- Lambrechts, K.; Balestra, C.; Theron, M.; Henckes, A.; Galinat, H.; Mignant, F.; Belhomme, M.; Pontier, J.-M.; Guerrero, F. Venous gas emboli are involved in post-dive macro, but not microvascular dysfunction. Eur. J. Appl. Physiol. 2017, 117, 335–344. [Google Scholar] [CrossRef]
- Obad, A.; Valic, Z.; Palada, I.; Brubakk, A.O.; Modun, D.; Dujić, Z. Antioxidant pretreatment and reduced arterial endothelial dysfunction after diving. Aviat. Space Environ. Med. 2007, 78, 1114–1120. [Google Scholar] [CrossRef]
- Poukens, V.; Glasgow, B.J.; Demer, J.L. Nonvascular contractile cells in sclera and choroid of humans and monkeys. Investig. Ophthalmol. Vis. Sci. 1998, 39, 1765–1774. [Google Scholar]
- Akahori, T.; Iwase, T.; Yamamoto, K.; Ra, E.; Terasaki, H. Changes in Choroidal Blood Flow and Morphology in Response to Increase in Intraocular Pressure. Investig. Opthalmol. Vis. Sci. 2017, 58, 5076–5085. [Google Scholar] [CrossRef] [PubMed] [Green Version]
- Zhang, X.; Cole, E.; Pillar, A.; Lane, M.; Waheed, N.; Adhi, M.; Magder, L.; Quigley, H.; Saeedi, O. The Effect of Change in Intraocular Pressure on Choroidal Structure in Glaucomatous Eyes. Investig. Opthalmol. Vis. Sci. 2017, 58, 3278–3285. [Google Scholar] [CrossRef] [PubMed] [Green Version]
- Kara, N.; Baz, O.; Altan, C.; Satana, B.; Kurt, T.; Demirok, A. Changes in choroidal thickness, axial length, and ocular perfusion pressure accompanying successful glaucoma filtration surgery. Eye 2013, 27, 940–945. [Google Scholar] [CrossRef] [PubMed] [Green Version]
- Silva, D.; Lopes, A.S.; Henriques, S.; Lisboa, M.; Pinto, S.; Vaz, F.T.; Prieto, I. Changes in choroidal thickness following trabeculectomy and its correlation with the decline in intraocular pressure. Int. Ophthalmol. 2018, 39, 1097–1104. [Google Scholar] [CrossRef] [PubMed]
- Bouillot, A.; Pierru, A.; Blumen-Ohana, E.; Brasnu, E.; Baudouin, C.; Labbé, A. Changes in choroidal thickness and optic nerve head morphology after filtering surgery: Nonpenetrating deep sclerectomy versus trabeculectomy. BMC Ophthalmol. 2019, 19, 24. [Google Scholar] [CrossRef] [PubMed]
- Wang, Y.X.; Jiang, R.; Ren, X.L.; Chen, J.D.; Shi, H.L.; Xu, L.; Bin Wei, W.; Jonas, J.B. Intraocular pressure elevation and choroidal thinning. Br. J. Ophthalmol. 2016, 100, 1676–1681. [Google Scholar] [CrossRef] [PubMed]
- Mauget-Faÿsse, M.; Arej, N.; Paternoster, M.; Zuber, K.; Derrien, S.; Thevenin, S.; Alonso, A.-S.; Salviat, F.; Lafolie, J.; Vasseur, V. Retinal and choroidal blood flow variations after an endurance exercise: A real-life pilot study at the Paris Marathon. J. Sci. Med. Sport 2021, 24, 1100–1104. [Google Scholar] [CrossRef]
- Sayin, N.; Kara, N.; Pekel, G.; Altinkaynak, H. Choroidal thickness changes after dynamic exercise as measured by spectral-domain optical coherence tomography. Indian J. Ophthalmol. 2015, 63, 445–450. [Google Scholar] [CrossRef]
- Hong, J.; Zhang, H.; Kuo, D.S.; Wang, H.; Huo, Y.; Yang, D.; Wang, N. The Short-Term Effects of Exercise on Intraocular Pressure, Choroidal Thickness and Axial Length. PLoS ONE 2014, 9, e104294. [Google Scholar] [CrossRef]
- Iovino, C.; Chhablani, J.; Rasheed, M.A.; Tatti, F.; Bernabei, F.; Pellegrini, M.; Giannaccare, G.; Peiretti, E. Effects of different mydriatics on the choroidal vascularity in healthy subjects. Eye 2021, 35, 913–918. [Google Scholar] [CrossRef]
- Dujić, Ž.; Palada, I.; Valic, Z.; Duplančić, D.; Obad, A.; Wisløff, U.; Brubakk, A.O. Exogenous Nitric Oxide and Bubble Formation in Divers. Med. Sci. Sports Exerc. 2006, 38, 1432–1435. [Google Scholar] [CrossRef] [Green Version]
- Wisløff, U.; Richardson, R.S.; Brubakk, A.O. Exercise and nitric oxide prevent bubble formation: A novel approach to the prevention of decompression sickness? J. Physiol. 2004, 555, 825–829. [Google Scholar] [CrossRef]
- Wisløff, U.; Richardson, R.S.; Brubakk, A.O. Nos inhibition increases bubble formation and reduces survival in sedentary but not exercised rats. J. Physiol. 2003, 546, 577–582. [Google Scholar] [CrossRef]
- Lautridou, J.; Dugrenot, E.; Amérand, A.; Guernec, A.; Pichavant-Rafini, K.; Goanvec, C.; Inizan, M.; Albacete, G.; Belhomme, M.; Galinat, H.; et al. Physiological characteristics associated with increased resistance to decompression sickness in male and female rats. J. Appl. Physiol. 2020, 129, 612–625. [Google Scholar] [CrossRef]
- Imbert, J.-P.; Egi, S.M.; Germonpré, P.; Balestra, C. Static Metabolic Bubbles as Precursors of Vascular Gas Emboli During Divers’ Decompression: A Hypothesis Explaining Bubbling Variability. Front. Physiol. 2019, 10, 807. [Google Scholar] [CrossRef] [Green Version]
- Marinovic, J.; Ljubkovic, M.; Breskovic, T.; Gunjaca, G.; Obad, A.; Modun, D.; Bilopavlovic, N.; Tsikas, D.; Dujic, Z. Effects of successive air and nitrox dives on human vascular function. Eur. J. Appl. Physiol. 2011, 112, 2131–2137. [Google Scholar] [CrossRef]
- Brubakk, A.O.; Duplancic, D.; Valic, Z.; Palada, I.; Obad, A.; Bakovic, D.; Wisløff, U.; Dujic, Z. A single air dive reduces arterial endothelial function in man. J. Physiol. 2005, 566, 901–906. [Google Scholar] [CrossRef] [Green Version]
- Daruich, A.; Matet, A.; Dirani, A.; Bousquet, E.; Zhao, M.; Farman, N.; Jaisser, F.; Behar-Cohen, F. Central serous chorioretinopathy: Recent findings and new physiopathology hypothesis. Prog. Retin. Eye Res. 2015, 48, 82–118. [Google Scholar] [CrossRef] [Green Version]
- Dietrich, K.C. Fighter Pilot with Recurrent Central Serous Chorioretinopathy. Aerosp. Med. Hum. Perform. 2016, 87, 901–905. [Google Scholar] [CrossRef]
- Gross, M.; Froom, P.; Tendler, Y.; Mishori, M.; Ribak, J. Central serous retinopathy (choroidopathy) in pilots. Aviat. Space Environ. Med. 1986, 57, 457–458. [Google Scholar]
- Newman, D.G. Central serous retinopathy with permanent visual deficit in a commercial air transport pilot: A case report. Aviat. Space Environ. Med. 2002, 73, 1122–1126. [Google Scholar]
- Richmond, M.R.R.; Rings, M.M. Recurrent Central Serous Retinopathy with Permanent Visual Loss in a U.S. Naval Fighter Pilot. Mil. Med. 2018, 183, e671–e675. [Google Scholar] [CrossRef] [Green Version]
- Ide Central Serous Chorioretinopathy Following Hypobaric Chamber Exposure. Aviat. Space Environ. Med. 2014, 85, 1053–1055. [CrossRef]
- Fischer, M.D.; Schatz, A.; Seitz, I.P.; Schommer, K.; Bartz-Schmidt, K.U.; Gekeler, F.; Willmann, G. Reversible Increase of Central Choroidal Thickness During High-Altitude Exposure. Investig. Opthalmol. Vis. Sci. 2015, 56, 4499–4503. [Google Scholar] [CrossRef] [Green Version]
- Polkinghorne, P.; Cross, M.; Sehmi, K.; Minassian, D.; Bird, A. Ocular Fundus Lesions in Divers. Lancet 1988, 332, 1381–1383. [Google Scholar] [CrossRef]
- Holden, R.; Morsman, C.D.; Lane, C.M. Ocular fundus lesions in sports divers using safe diving practices. Br. J. Sports Med. 1992, 26, 90–92. [Google Scholar] [CrossRef] [Green Version]
- Peyraud-Gilly, V.M.; Daubas, P.; Joly, T.; Filliard, G.; Monroux-Rousseau, S. Macular functions in professional divers. J. Français d’Ophtalmol. 2000, 23, 472–474. [Google Scholar]
- Murrison, A.W.; Pethybridge, R.J.; Rintoul, A.J.; Jeffrey, M.N.; Sehmi, K.; Bird, A.C. Retinal angiography in divers. Occup. Environ. Med. 1996, 53, 339–342. [Google Scholar] [CrossRef] [Green Version]
- McMonnies, C.W. Intraocular pressure and glaucoma: Is physical exercise beneficial or a risk? J. Optom. 2016, 9, 139–147. [Google Scholar] [CrossRef] [Green Version]
- Risner, D.; Ehrlich, R.; Kheradiya, N.S.; Siesky, B.; McCranor, L.; Harris, A. Effects of exercise on intraocular pressure and ocular blood flow: A review. J. Glaucoma 2009, 18, 429–436. [Google Scholar] [CrossRef]
- Yan, X.; Li, M.; Song, Y.; Guo, J.; Zhao, Y.; Chen, W.; Zhang, H. Influence of Exercise on Intraocular Pressure, Schlemm’s Canal, and the Trabecular Meshwork. Investig. Opthalmol. Vis. Sci. 2016, 57, 4733–4739. [Google Scholar] [CrossRef] [PubMed] [Green Version]
- Goenadi, C.J.; Law, D.Z.; Lee, J.W.; Ong, E.L.; Chee, W.K.; Cheng, J. The Effect of a Diving Mask on Intraocular Pressure in a Healthy Population. Case Rep. Ophthalmol. 2016, 7, 328–332. [Google Scholar] [CrossRef] [PubMed]
- Guzmán, A.F.; Castilla, A.A.; Guarnieri, F.A.; Rodríguez, F.R. Intraocular pressure: Goldmann tonometry, computational model, and calibration equation. J. Glaucoma 2013, 22, 10–14. [Google Scholar] [CrossRef] [PubMed]
- Fadini, G.P.; Pagano, C.; Baesso, I.; Kotsafti, O.; Doro, D.; De Kreutzenberg, S.V.; Avogaro, A.; Agostini, C.; Dorigo, M.T. Reduced endothelial progenitor cells and brachial artery flow-mediated dilation as evidence of endothelial dysfunction in ocular hypertension and primary open-angle glaucoma. Acta Ophthalmol. 2010, 88, 135–141. [Google Scholar] [CrossRef]
- Maverick, K.J.; Conners, M.S. Corneal Thickness and Intraocular Pressure Changes Associated with Scuba Diving. Investig. Ophthalmol. Vis. Sci. 2003, 44, 2571. [Google Scholar]
- Pukrushpan, P.; Tulvatana, W.; Kulvichit, K. Intraocular pressure change following application of 1% tropicamide for diagnostic mydriasis. Acta Ophthalmol. Scand. 2005, 84, 268–270. [Google Scholar] [CrossRef]
- Marchini, G.; Babighian, S.; Tosi, R.; Perfetti, S.; Bonomi, L. Comparative Study of the Effects of 2% Ibopamine, 10% Phenylephrine, and 1% Tropicamide on the Anterior Segment. Investig. Opthalmol. Vis. Sci. 2003, 44, 281–289. [Google Scholar] [CrossRef] [Green Version]
- Oltulu, R.; Satirtav, G.; Altunkaya, O.; Bitirgen, G.; Okka, M. Effect of mydriasis induced by topical 0.5% tropicamide instillation on the corneal biomechanical properties in healthy individuals measured by ocular response analyzer. Cutan. Ocul. Toxicol. 2014, 34, 35–37. [Google Scholar] [CrossRef]
- Qian, C.X.-Y.; Duperré, J.; Hassanaly, S.; Harissi-Dagher, M. Pre- versus post-dilation changes in intraocular pressure: Their clinical significance. Can. J. Ophthalmol. 2012, 47, 448–452. [Google Scholar] [CrossRef]
- Atalay, E.; Tamçelik, N.; Arici, C.; Özkök, A.; Dastan, M.; Arıcı, C. The change in intraocular pressure after pupillary dilation in eyes with pseudoexfoliation glaucoma, primary open angle glaucoma, and eyes of normal subjects. Int. Ophthalmol. 2014, 35, 215–219. [Google Scholar] [CrossRef]

| Mean ± SD | Pre-Dive | 30 min Post-Dive | p-Value | 60 min Post-Dive | p-Value |
|---|---|---|---|---|---|
| SFCT (%) | 100 | 96.6 (±13.89) | 0.016 | 98.4 (±5.7) | 0.21 (ns) |
| IOP (%) | 100 | 88.05 (±10.03) | <0.0001 | 91.4 (±10.3) | <0.0001 |
| Pachymetry (%) | 100 | 101.6 (±1.0) | 0.015 | 100.2 (±1.4) | ns |
| Mean ± SD | Pre-Dive | 30 min Post-Dive | p-Value | 60 min Post-Dive | p-Value |
|---|---|---|---|---|---|
| SFCT (µm) | 327.1 (±102.0) | 318.1 (±109.7) | 0.0326 | 322.2 (±102.1) | 0.2434 |
| IOP (mmHg) | 16.4 (±2.009) | 14.3 (±2.27) | <0.0001 | 14.98 (±2.67) | <0.0001 |
| Pachymetry (µm) | 559.3 (±27.83) | 566.5 (±33.53) | 0.0120 | 562.9 (±28.62) | ns |
Publisher’s Note: MDPI stays neutral with regard to jurisdictional claims in published maps and institutional affiliations. |
© 2022 by the authors. Licensee MDPI, Basel, Switzerland. This article is an open access article distributed under the terms and conditions of the Creative Commons Attribution (CC BY) license (https://creativecommons.org/licenses/by/4.0/).
Share and Cite
Deleu, L.; Catherine, J.; Postelmans, L.; Balestra, C. Effect of SCUBA Diving on Ophthalmic Parameters. Medicina 2022, 58, 408. https://doi.org/10.3390/medicina58030408
Deleu L, Catherine J, Postelmans L, Balestra C. Effect of SCUBA Diving on Ophthalmic Parameters. Medicina. 2022; 58(3):408. https://doi.org/10.3390/medicina58030408
Chicago/Turabian StyleDeleu, Laurent, Janet Catherine, Laurence Postelmans, and Costantino Balestra. 2022. "Effect of SCUBA Diving on Ophthalmic Parameters" Medicina 58, no. 3: 408. https://doi.org/10.3390/medicina58030408
APA StyleDeleu, L., Catherine, J., Postelmans, L., & Balestra, C. (2022). Effect of SCUBA Diving on Ophthalmic Parameters. Medicina, 58(3), 408. https://doi.org/10.3390/medicina58030408







